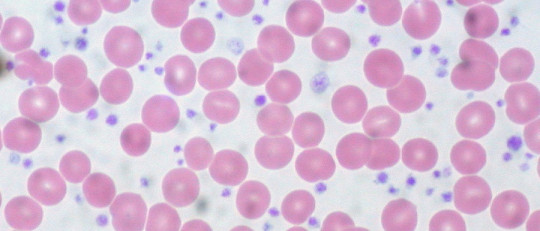
Trombocitopenia

Aunque la primera imagen que se nos suele venir a la mente cuando pensamos en un embarazo es la de una madre junto a su pareja, unidos y alegres a la espera de un niño, ésta no se ajusta a lo que tiende a ocurrir en la realidad. Y es que tal idealización no ilustra la antesala a la maternidad, aquello que le precede a la gestación: el momento de ponderar qué consecuencias podría acarrear decidir tener un hijo o hija antes de dar el paso.
Este proceso no es color de rosas, ya que requiere poner sobre la balanza distintas cuestiones como ponderar en qué medida la llegada del nuevo niño o niña modificará la vida cotidiana de sus padres, cómo incidirá en sus trabajos, sus pasatiempos o incluso su economía.
De tal modo, esta perspectiva pone a la luz las contradicciones que forman parte del proceso de planear ser padres y que, sin embargo, no están ilustradas en la imagen romántica que señalábamos con anterioridad. Una vez sorteadas estas dificultades, dentro de las problemáticas invisibles que pueden encontrar las parejas a la hora de dar finalmente el paso de buscar un niño o niña, específicamente las madres, es sentir altos niveles de estrés al no quedar embarazadas a pesar de desearlo. En este artículo desarrollaremos los distintos aspectos que comprende este tema.
- Artículo relacionado: "Psicología perinatal: ¿qué es y qué funciones realiza?"
No poder quedar embarazada y su relación con el estrés
Primeramente, es importante señalar que es vasta la literatura científica alrededor de la relación entre la experiencia de tener dificultades para quedar embarazada y el estrés. Los estudios tienden a centrarse en la infertilidad —lo cual no supone que todas las personas que tengan dificultades para concebir un hijo sean infértiles—, pero que no obstante se tratan de investigaciones que enfatizan la siguiente idea: los obstáculos que atraviesan estas parejas van más allá de la infertilidad como condición médica. En otras palabras, no poder tener un hijo es una experiencia que incide profundamente en la vida de la persona a nivel psicológico y en su relación de pareja.
Esto se debe a que la imposibilidad de dar inicio a una nueva etapa en su vida implica la frustración de un proyecto personal y compartido de cara al futuro, dando pie a la incertidumbre y a nuevas inseguridades; en definitiva, haciendo de esta situación una experiencia estresante.
Además, el estrés no se reduce al hecho exclusivo de no quedar embarazada sino a los tratamientos que existen para la infertilidad en caso de haberla. No es ninguna novedad cuán doloroso puede ser este proceso para una pareja. En líneas generales, las parejas que encuentran dificultades para tener hijos presentan un nivel de ansiedad aumentado, tienen efectos negativos en la relación y el funcionamiento sexual en la pareja, como así también disminuye la autoestima de ambos. Por otra parte, los estudios suelen estar de acuerdo en que las mujeres tienden a percibir mayor estrés de la experiencia de infertilidad respecto a los hombres, incluso cuando el diagnóstico no se les atribuye directamente a ellas.
Esto podría fundamentarse en que aún subyace un fuerte mandato que dictamina el deber ser madre dentro de las sociedades occidentales, el cual perjudica sustancialmente no sólo a las mujeres que tienen dificultades para quedar embarazadas sino también a aquellas que no lo desean.
- Quizás te interese: "Tipos de estrés y sus desencadenantes"
¿Qué hacer ante le exceso de estrés por no concebir un bebé?
Algo importante a aclarar es que sentirse estresada ante esta situación es completamente normal y esperable. En sí mismo, el estrés es normal, ya que si no tuviésemos la capacidad de percibir una amenaza o peligro en el medio que nos rodea no podríamos tomar decisiones acordes con las circunstancias ante las que nos enfrentamos. De hecho, también es esperable que la pareja presente incluso otros tipos de respuestas emocionales, como ansiedad, miedo o tristeza por las trabas que están interponiéndose entre ellos y el proyecto que desean concretar.
Lo importante no es que la situación no les afecte, sino que el modo de afrontamiento al estrés que pongan en juego sea suficiente para aceptar la situación que genera malestar. Es de vital importancia tener esto en cuenta ya que actualmente, desde la psicología científica, no es posible afirmar que los conflictos emocionales o psíquicos tengan una relación causal con la infertilidad; pero lo que sí está dentro del campo de acción de las personas es poner en práctica distintas formas de enfrentarse a esta situación estresante. Y es que, además, poner en práctica estrategias de afrontamiento al estrés podrá no solo ayudar a tomar decisiones más conscientes, sino que se ha demostrado que pueden mejorar el bienestar percibido por ambos padres y prolongar la permanencia de los tratamientos para la infertilidad.
- Artículo relacionado: "Los problemas psicológicos derivados de la infertilidad"
Técnicas para afrontar el estrés
En este punto, es fundamental subrayar cuán importante es la empatía y el acompañamiento mutuo de la pareja, como así también la cercanía por parte de la red familiar y de amistades o el apoyo de un profesional de la salud mental. Por nuestra parte, y en línea con lo expuesto, proponemos una serie de técnicas de afrontamiento al estrés para los momentos críticos que puede experimentar una mujer por no quedar embarazada.
- Comunicar y expresar las emociones con alguien de confianza: Esto puede ser particularmente útil llevarlo a cabo con otra persona que está atravesando o atravesó la misma condición para compartir experiencias.
- Practicar técnicas enfocadas en centrar la atención en el momento presente, como prácticas Mindfulness o técnicas basadas en éste, como puede ser el body scan o escáner corporal.
- Hacer ejercicio o practicar algún deporte.
- Actividades expresivas como la escritura o journaling, el canto, baile o dibujo. Esto podría servir para aliviar algunos estados emocionales intensos, en particular si desarrollar la creatividad y la expresividad es algo valioso para la persona.

Tomas Santa Cecilia
Tomas Santa Cecilia
Psicologo Consultor: Master en Psicología Cognitivo Conductual
- Acudir a psicoterapia, con un profesional especializado en el tema capaz de brindarle apoyo y acompañamiento.


Newsletter PyM
La pasión por la psicología también en tu email
Únete y recibe artículos y contenidos exclusivos
Suscribiéndote aceptas la política de privacidad